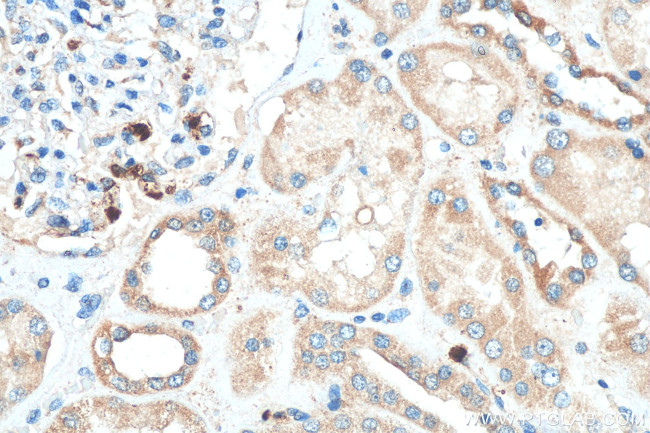
KIAA0317 Antibody in Immunohistochemistry (Paraffin) (IHC (P))

Search
Proteintech
KIAA0317 Polyclonal Antibody
{{$productOrderCtrl.translations['antibody.pdp.commerceCard.promotion.promotions']}}
{{$productOrderCtrl.translations['antibody.pdp.commerceCard.promotion.viewpromo']}}
{{$productOrderCtrl.translations['antibody.pdp.commerceCard.promotion.promocode']}}: {{promo.promoCode}} {{promo.promoTitle}} {{promo.promoDescription}}. {{$productOrderCtrl.translations['antibody.pdp.commerceCard.promotion.learnmore']}}
产品信息
25623-1-AP
种属反应
宿主/亚型
分类
类型
抗原
偶联物
形式
浓度
规格
纯化类型
保存液
内含物
保存条件
运输条件
产品详细信息
Immunogen sequence: GHSMAFRVHL FYKNGQPFPA HRPVGLRVHI SHVELAVEIP VNQEVLQEPN SNVVKVAFTV RKAGRYEITV KLGGLNVAYS PYYKIFQPGM VVPSKTKIVC HFSTLVLTCG QPHTLQIVPR DEYDNPTNNS MSLRDEHNYT LSIHELGPQE EESTGVSFEK SVTSNRQTFQ VFLRLTLHSR GCFHACISYQ NQPINNGEFD IIVLSEDEKN IVERNVSTSG VSIYFEAYLY NATNCSSTPW HLPPMHMTSS QRRPSTAVDE EDEDS
靶标信息
KIAA0317 contains 1 filamin repeat and 1 HECT (E6AP-type E3 ubiquitin-protein ligase) domain. The exact function of KIAA0317 remains unknown.
仅用于科研。不用于诊断过程。未经明确授权不得转售。
篇参考文献 (0)
生物信息学
蛋白别名: Apoptosis-resistant E3 ubiquitin protein ligase 1; Apoptosis-resistant HECT-type E3 ubiquitin transferase 1; fibrosis-inducing E3 ligase 1; KIAA0317; protein KIAA0317; unnamed protein product
基因别名: 1110018G07Rik; AI649076; AREL1; AW610792; FIEL1; KIAA0317; mKIAA0317
UniProt ID: (Human) O15033, (Mouse) Q8CHG5
Entrez Gene ID: (Human) 9870, (Mouse) 68497